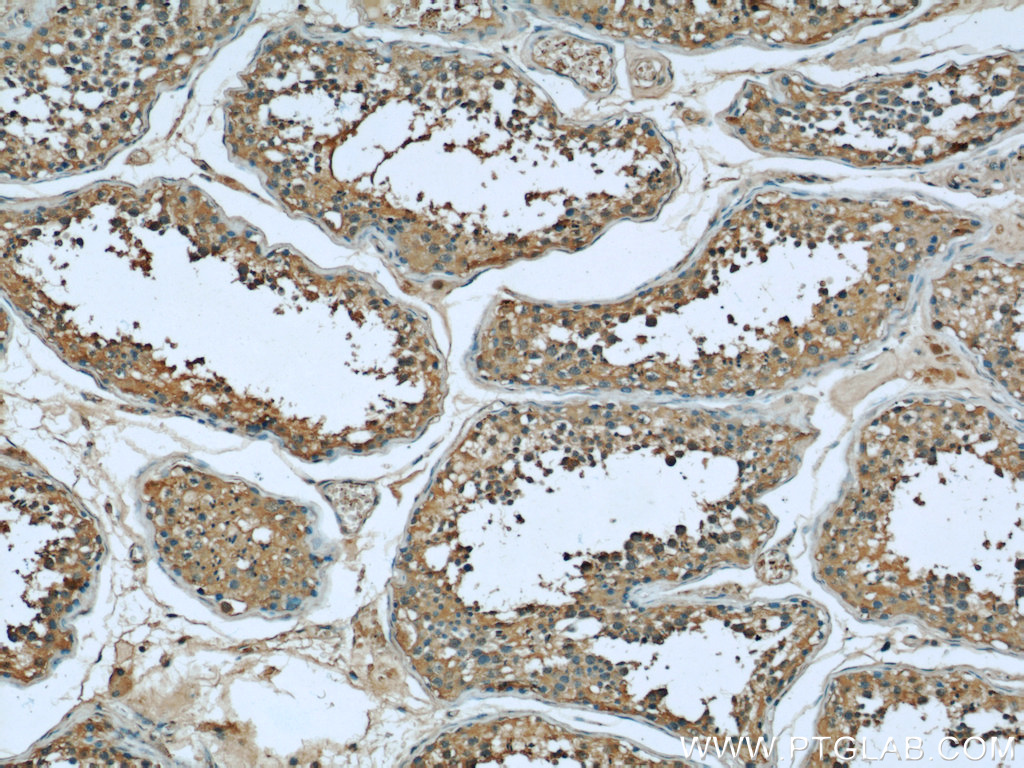

验证数据展示
经过测试的应用
| Positive WB detected in | Jurkat cells, A431 cells, HeLa cells, Ramos cells, K-562 cells, Raw 264.7 cells |
| Positive IHC detected in | human breast cancer tissue, human lymphoma tissue, human testis tissue, human colon tissue Note: suggested antigen retrieval with TE buffer pH 9.0; (*) Alternatively, antigen retrieval may be performed with citrate buffer pH 6.0 |
| Positive IF/ICC detected in | HeLa cells, HepG2 cells |
| Positive FC (Intra) detected in | HeLa cells |
推荐稀释比
| 应用 | 推荐稀释比 |
|---|---|
| Western Blot (WB) | WB : 1:2000-1:20000 |
| Immunohistochemistry (IHC) | IHC : 1:200-1:600 |
| Immunofluorescence (IF)/ICC | IF/ICC : 1:200-1:800 |
| Flow Cytometry (FC) (INTRA) | FC (INTRA) : 0.40 ug per 10^6 cells in a 100 µl suspension |
| It is recommended that this reagent should be titrated in each testing system to obtain optimal results. | |
| Sample-dependent, Check data in validation data gallery. | |
产品信息
66020-1-Ig targets BCL2L1 in WB, IHC, IF/ICC, FC (Intra), IP, CoIP, ELISA applications and shows reactivity with human, mouse, rat samples.
| 经测试应用 | WB, IHC, IF/ICC, FC (Intra), ELISA Application Description |
| 文献引用应用 | WB, IHC, IF, IP, CoIP |
| 经测试反应性 | human, mouse, rat |
| 文献引用反应性 | human, mouse, hamster |
| 免疫原 |
CatNo: Ag18037 Product name: Recombinant human Bcl-xL protein Source: e coli.-derived, PET28a Tag: 6*His Domain: 1-233 aa of BC019307 Sequence: MSQSNRELVVDFLSYKLSQKGYSWSQFSDVEENRTEAPEGTESEMETPSAINGNPSWHLADSPAVNGATGHSSSLDAREVIPMAAVKQALREAGDEFELRYRRAFSDLTSQLHITPGTAYQSFEQVVNELFRDGVNWGRIVAFFSFGGALCVESVDKEMQVLVSRIAAWMATYLNDHLEPWIQENGGWDTFVELYGNNAAAESRKGQERFNRWFLTGMTVAGVVLLGSLFSRK 种属同源性预测 |
| 宿主/亚型 | Mouse / IgG2b |
| 抗体类别 | Monoclonal |
| 产品类型 | Antibody |
| 全称 | BCL2-like 1 |
| 别名 | Bcl-xL, 4C12A6, Apoptosis regulator Bcl X, Apoptosis regulator Bcl-X, Bcl2-L-1 |
| 计算分子量 | 26 kDa |
| 观测分子量 | 30 kDa |
| GenBank蛋白编号 | BC019307 |
| 基因名称 | BCL2L1 |
| Gene ID (NCBI) | 598 |
| RRID | AB_11042315 |
| 偶联类型 | Unconjugated |
| 形式 | Liquid |
| 纯化方式 | Protein A purification |
| UNIPROT ID | Q07817 |
| 储存缓冲液 | PBS with 0.02% sodium azide and 50% glycerol, pH 7.3. |
| 储存条件 | Store at -20°C. Stable for one year after shipment. Aliquoting is unnecessary for -20oC storage. |
背景介绍
BCL2L1 is a member of the BCL-2 protein family. BCL2L1 is expressed as three isoforms, Bcl-X(L),Bcl-X(s) and Bcl-X(beta), and is located at the outer mitochondrial membrane. The Bcl-XL isoform is a 233 amino acid protein, acting as an apoptotic inhibitor. Bcl-XL can forms heterodimers with BAX, BAK or BCL2, and the heterodimerization with BAX does not seem to be required for anti-apoptotic activity. The Bcl-XS isoform is a shorter variant that is 178 amino acids in length and lacks a 63 amino acid region (amino acids 126-188), acting as an apoptotic activator.
实验方案
| Product Specific Protocols | |
|---|---|
| FC protocol for BCL2L1 antibody 66020-1-Ig | Download protocol |
| IF protocol for BCL2L1 antibody 66020-1-Ig | Download protocol |
| IHC protocol for BCL2L1 antibody 66020-1-Ig | Download protocol |
| WB protocol for BCL2L1 antibody 66020-1-Ig | Download protocol |
| Standard Protocols | |
|---|---|
| Click here to view our Standard Protocols |
发表文章
| Species | Application | Title |
|---|---|---|
Autophagy Increased mitochondrial fission promotes autophagy and hepatocellular carcinoma cell survival through the ROS-modulated coordinated regulation of the NFKB and TP53 pathways. | ||
J Immunother Cancer Switch receptor T3/28 improves long-term persistence and antitumor efficacy of CAR-T cells | ||
Acta Pharmacol Sin Targeting proteasomal deubiquitinases USP14 and UCHL5 with b-AP15 reduces 5-fluorouracil resistance in colorectal cancer cells | ||
Blood Cancer J The combination of CUDC-907 and gilteritinib shows promising in vitro and in vivo antileukemic activity against FLT3-ITD AML. | ||
Antioxid Redox Signal MCUR1-Mediated Mitochondrial Calcium Signaling Facilitates Cell Survival of Hepatocellular Carcinoma via Reactive Oxygen Species-Dependent P53 Degradation. | ||
J Med Chem Design, Synthesis, and Activity Evaluation of Novel Acyclic Nucleosides as Potential Anticancer Agents In Vitro and In Vivo. |